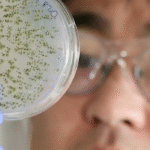
original e1415577527387 أدوية سرطان مفتوحة المصدر مجلة نقطة العلمية

على الرغم من أن الأشباح لا توجد إلّا في أذهاننا، إلّا أن العلماء استطاعوا التوصل للعثور عليها، فبحسب دراسة صادرة عن المدرسة التطبيقية الاتحادية في لوزان (EPFL)، فإن غالبية المرضى الذين يعانون من حالات عصبية أو نفسية يبلغون عن شعورهم بوجود كيان غريب بالقرب منهم، لذلك قام الباحثون في (EPFL) في سويسرا بمحاولة إعادة تطبيق هذا الوهم الشبحي في المختبر.
في 29 حزيران من عام 1970، أبلغ متسلق الجبال (راينولد ميسنر) عن مروره بتجربة غير عادية عندما كان يتسلق مع أخيه قمة جبل نانغا باربات، حيث أفاد أنه في الجو المتجمد والأرض الواسعة الجرداء وضمن ظروف نقص الأكسجين، أحس بوجود شخص ثالث معهما، وقد حدد موقعه لأنه أحس بوجوده إلى يمينه وعلى بعد خطوات قليلة منه، خارج مجال الرؤية لديه.
إلى جانب هذه القصة، فقد تم الإبلاغ عن العديد من القصص الأخرى المشابهة، وليس فقط من قبل متسلقي الجبال والمستكشفين، والناجين، والأرامل، بل أيضاً من قبل المرضى الذين يعانون من اضطرابات عصبية أو نفسية، حيث أنهم عادة ما يزعمون وجود كيان ما إلى جانبهم يمكنهم الشعور به ولكنهم لا يستطيعون رؤيته، شيء ما أقرب إلى الملاك الحارس أو الشيطان.
مؤخراً استطاع فريق بحث (أولاف بلانك) في EPFL)) الكشف عن مكان وجود هذا الشبح، حيث كان الفريق قادراً على إعادة خلق إحساس وهمي مماثل لحضور كائن ما في المختبر، واستطاعوا بذلك تقديم تفسير بسيط لهذه الحالة، فقد استطاع الباحثون اظهار أن “الشعور بوجود” كائن ما، هو في الحقيقية ناتج عن حصول تغيّرات في إشارات الدماغ الحسية، التي تشارك في توليد الوعي الذاتي من خلال دمج المعلومات القادمة من حركات الجسم وموقعه في الفراغ.
قام فريق (بلانك) في تجربتهم بالتدخل في سير المدخلات الحسية لدى المشاركين، بطريقة تمنع أدمغتهم من تحديد أن هذه الإشارات صادرة عن جسم الشخص نفسه، بحيث يتم تفسير هذه الإشارات على أنها صادرة عن شخص آخر، وقد تم نشر العمل في مجلة (Current Biology).
قام الباحثون أولاً بتحليل أدمغة 12 مريضاً يعانون من اضطرابات عصبية – أغلبهم يعانون من الصرع – وكانوا قد أبلغوا بوجود أشباح بحياتهم، ومن خلال هذا التحليل أظهر التصوير بالرنين المغناطيسي لأدمغة المرضى وجود تداخل في ثلاث مناطق قشرية، هي لحاء الانعزالية، والقشرة الجدارية أمامية، و اللحاء الصدغي الجداري، والجدير بالذكر أن هذه المناطق القشرية الثلاث تشارك في توليد الوعي الذاتي والحركة والإحساس وتحديد موقع الجسم في الفراغ – أي بمعنى آخر هي مسؤولة عن الاستقبال الحسي العميق- وعندما تتشارك هذه المراكز سوياً فإنها تسهم في معالجة الإشارات المتعدد الصادرة عن الحواس، وبالمجمل فإنها تسهم في تكوين الشخص لمفهوم صحيح عن نفسه.
بعد انتهائهم من تحليل البيانات المأخودة من أدمغة المرضى، قام العلماء بتنفيذ تجربة عدم الاتساق على أشخاص معصوبي الأعين، حيث كان يطلب من المشاركين القيام بحركة ما بأيديهم نحو الأمام، بينما يقوم روبوت يقف خلفهم في الوقت ذاته بإعادة حركاتهم ذاتها، ولمسهم من الخلف بذات الطريقة التي يتحركون بها، وكانت نتيجة هذه التجربة حصول نوع من التفاوت المكاني، ولكن بسبب الحركة المتزامنة للروبوت مع حركة المشاركين، كانت أدمغتهم قادرة على التكيف وتصحيح الخلل الحاصل فيها.
قام علماء الأعصاب بعد ذلك بتطبيق تأخير زمني بين حركة الأشخاص المشاركين في التجربة ولمس الروبوت لهم، وكانت النتيجة أن تغيير التزامن أدى إلى تشويه الإدراك الزماني والمكاني لدى المشاركين، مما مكّن الباحثين من إعادة خلق الوهم الشبحي في أذهان المشاركين ضمن المختبرات.
مع عدم دراية المشاركين بهدف التجربة، قام الباحثون بعد مرور حوالي ثلاث دقائق على انتهاء التجربة، بسؤال المشاركين عن شعورهم، وكانت إجابة العديد منهم أنهم شعروا بوجود حوالي أربعة “أشباح”، وحتى أن بعض المشاركين طالبوا بإيقاف إجراء التجربة لأن الشعور كان مزعجاً جداً لهم.
استطاع العلماء من خلال هذه التجربة إعادة خلق الإحساس بالوجود الشبحي في المختبرات لأول مرة، وبحسب (بلانك) فإن دل هذا على شيء، فإنه يدل على أن الاحساس بوجود الأشباح ممكن الحدوث في ظل الظروف الطبيعية، وذلك ببساطة من خلال تلقي الدماغ لإشارات حسية وحركية متضاربة، كما كان هذا النظام الروبوتي يحاكي أيضاً الأحاسيس التي تصيب بعض المرضى الذين يعانون من اضطرابات عقلية ويحاكي أيضاً الأحاسيس التي يشعر بها الأفراد الأصحاء الذين يمرون بظروف قاهرة، وهذا يؤكد أن هذه الظاهرة تتشكل بسبب حدوث تغيير في تصور الأشخاص لأجسامهم داخل ادمغتهم.
كان الهدف من هذه الدراسة بالإضافة إلى شرح هذه الظاهرة التي تعتبر مشتركة بين العديد من الثقافات، هو تأمين فهم أفضل لبعض الأعراض التي يعاني منها مرضى انفصام الشخصية، حيث غالباً ما يعاني هؤلاء المرضى من الهلوسة أو الأوهام المرتبطة بوجود كيان غريب قد يكون متمثلاً بسماع أصوات غريبة أو الشعور بنشاط غريب.
أخيراً، من المستبعد أن تؤدي هذه النتائج إلى ترك أي شخص لإيمانه بوجود الأشباح، ولكن مع ذلك، فإن هذه النتائج بالنسبة للعلماء، تعتبر أدلة تشير إلى أن هذه الكائنات لا توجد إلا في أذهاننا.